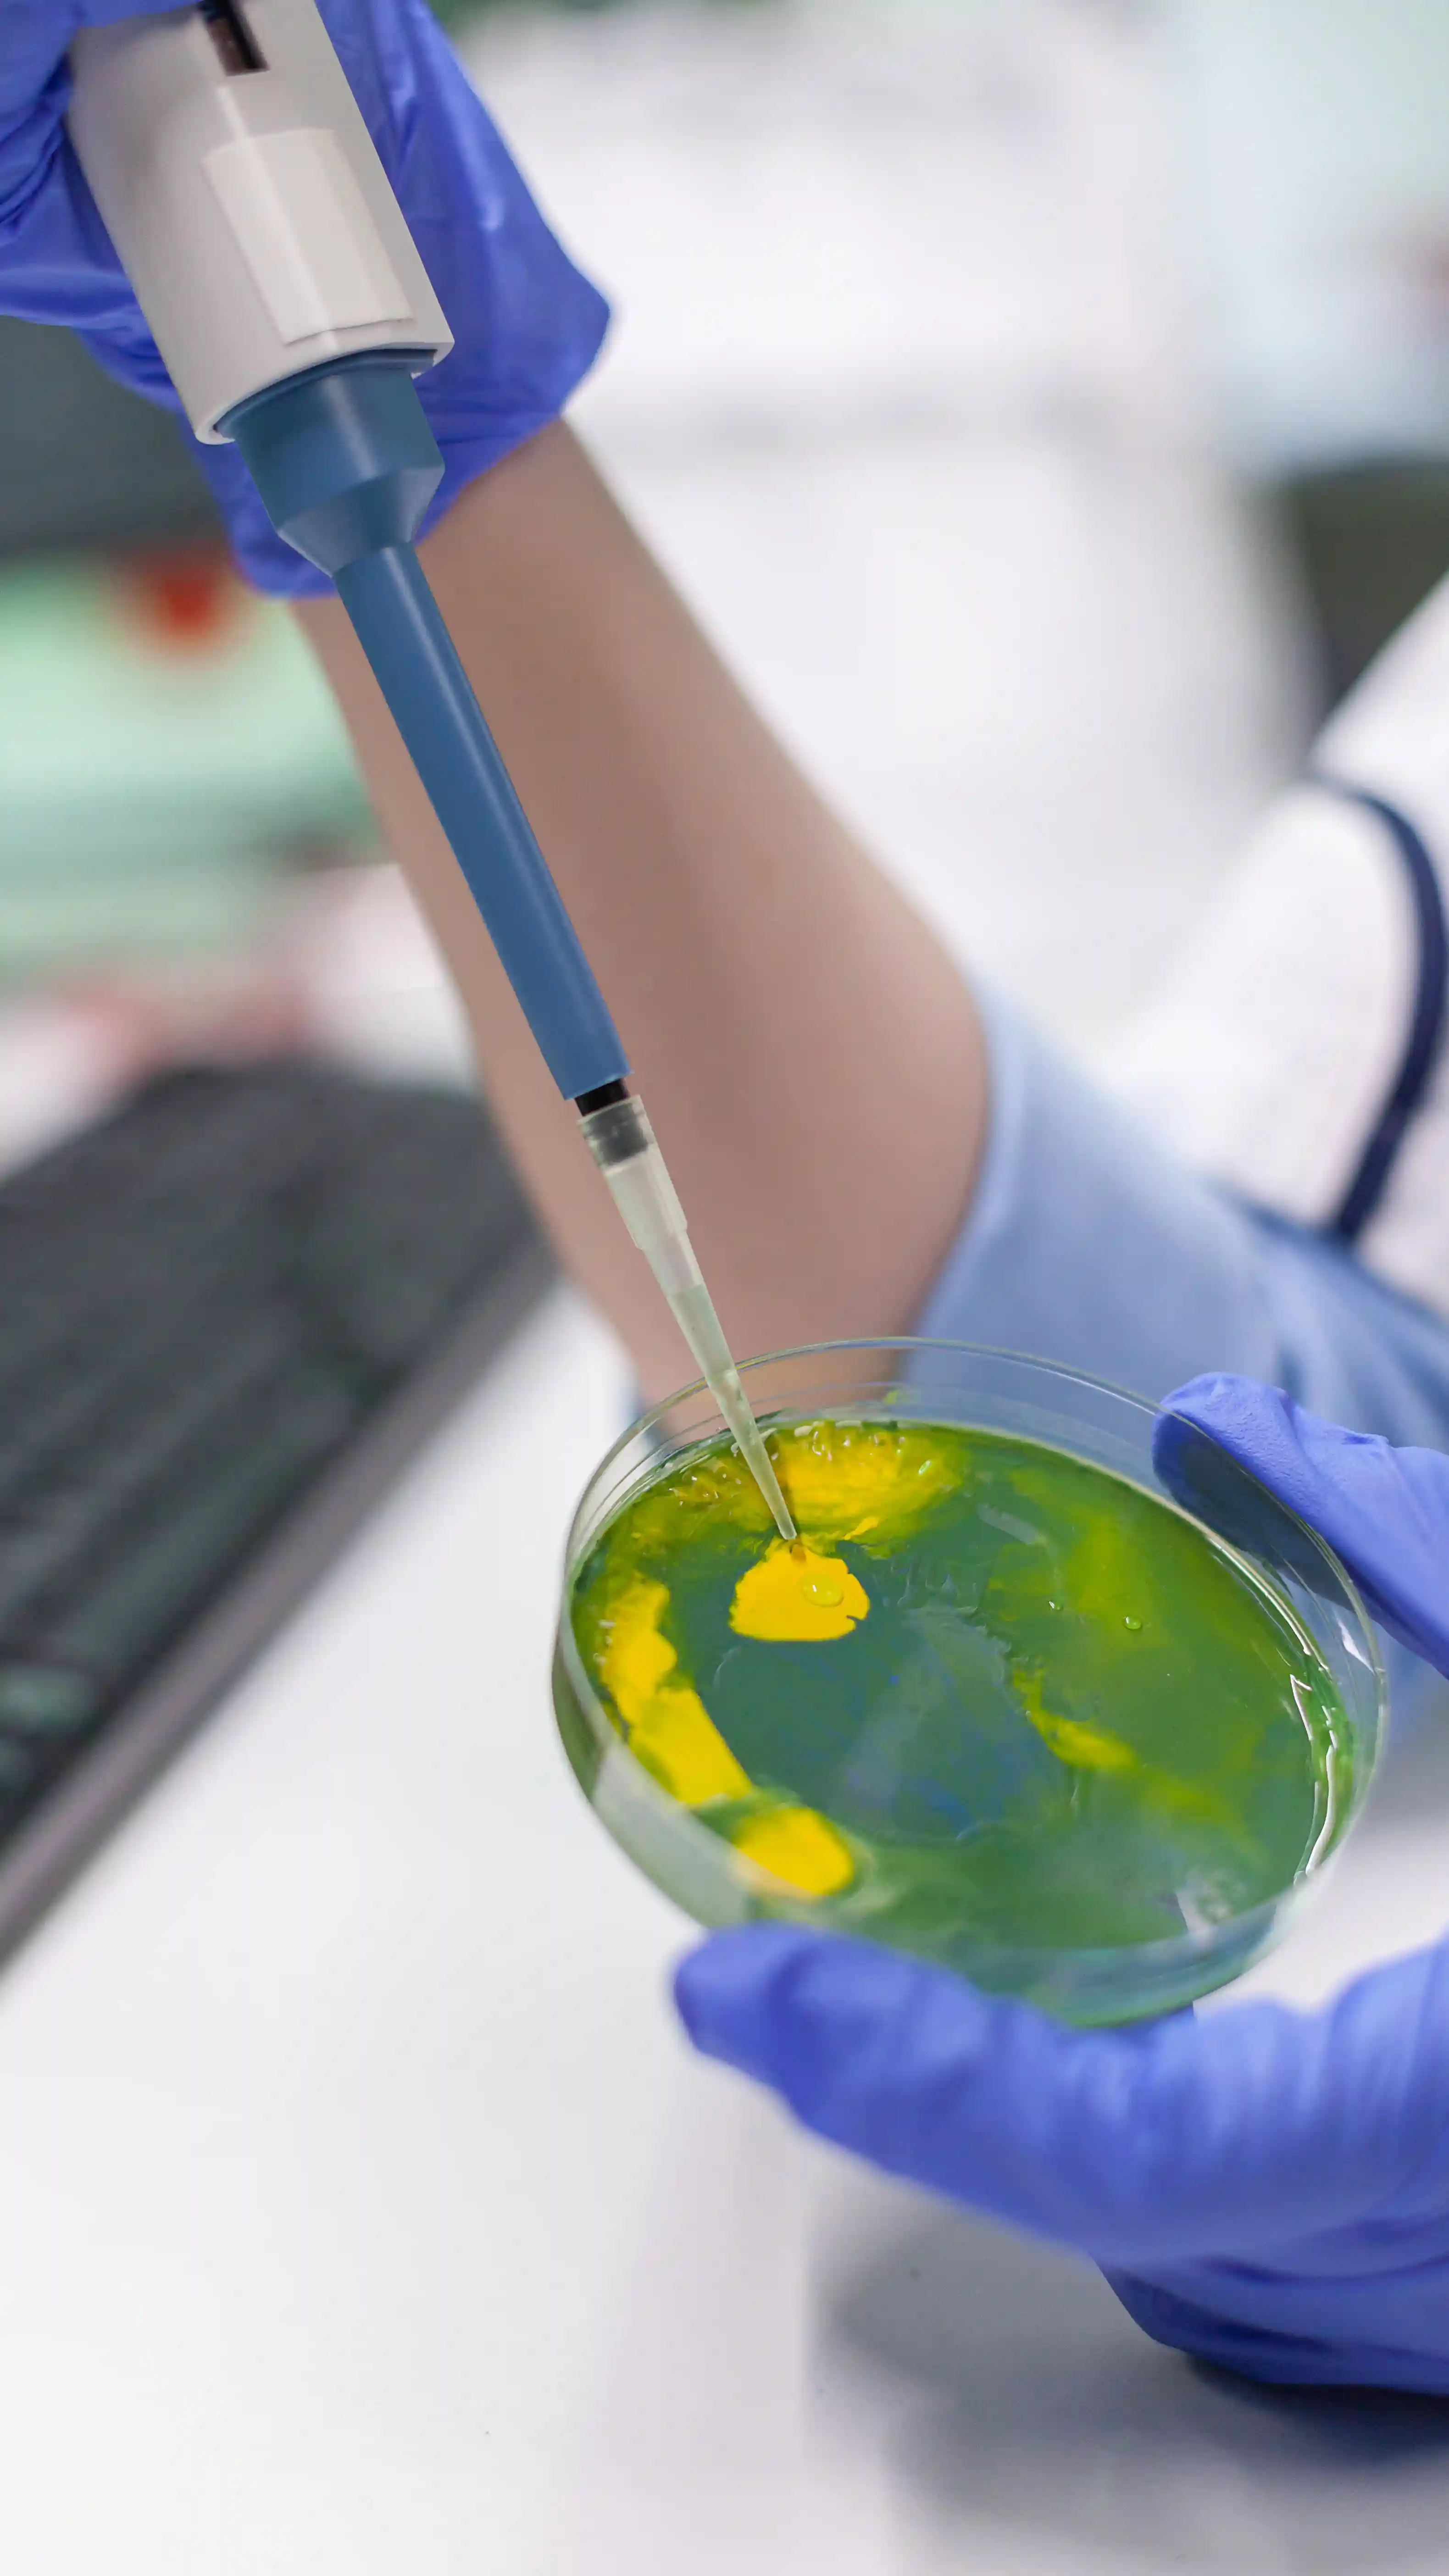
Test Kits for Milk & More

Premium Ingredients for Cheese, Dairy, and more
Cleaner labels. Longer shelf life. Better performance.
Global Innovation. Canadian Expertise.
At Ariomax, we supply science-driven ingredient systems that help dairy and food manufacturers enhance taste, texture, and shelf life — bridging global innovation with Canadian expertise. Our commitment to quality, transparency, and long-term collaboration ensures reliable performance and trusted partnerships across every market we serve.
Quality Excellence
Delivering high-standard ingredient systems with reliable, consistent, and clean-label performance.
Innovation Leadership
Advancing ingredient science through collaboration — creating smarter, sustainable food and dairy solutions.
Global Partnership
Building lasting relationships based on trust, transparency, and technical expertise — locally and globally.
Ingredients & Solutions:
Premium ingredient solutions that improve taste, texture, and consistency in dairy , food & Beverage applications.
Certified Quality & Safety
Supplied by global trusted partners with quality and dietary certifications — supported by local expertise.

FSSC 22000

HALAL

Kosher Certified

Proud Member
*Certifications vary by product and supplier.

Delivering Excellence inDairy Innovation
We provide sustainable, high-quality dairy solutions that nourish communities while maintaining the highest standards of quality and environmental responsibility.
Our commitment drives us to create innovative products that support both our customers' success and the well-being of our planet.
Markets & Applications
Connecting science with real-world dairy and food applications — from cheese and milk to beverages and beyond.

Cheese Solutions
Comprehensive ingredient systems for traditional and modern cheesemaking
Ariomax supports producers across all cheese types — from hard and semi-hard (Cheddar, Gouda, Parmesan) to soft and fresh (Feta, Cream Cheese, Labneh), as well as Mozzarella and processed cheeses with improved stretch, texture, and meltability. Our Biopreservatives , coagulants , enzymes and additives help optimize curd formation, flavor, and shelf life — delivering reliable, high-quality cheese production.
Latest Insights
Stay informed with the latest in food innovation — from our Knowledge Hub to news and events.

Ready to Experience Better Ingredients?
Discover how Ariomax can help you enhance quality, performance, and innovation in every dairy and food application.